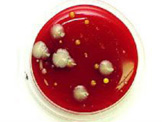

ErklÄrungen zu unseren Dienstleistungen im Bereich der Schimmelanalysen
 Zur Untersuchung der Ursache für die Schimmelbildung in Wohngebäuden gibt es verschiedene Vorgehensweisen, die wir zu sinnvollen Dienstleistungspaketen zusammengefasst haben. Das gleiche gilt auch für die unterschiedlichen Methoden zur Bestimmung der Keimbelastung im Material oder in der Luft. Vor der eigentlichen Schimmelanalyse erfolgt daher eine kurze Beratung über die sinnvollste Methode zur Erfassung des Problems und insbesondere zur Festlegung der Maßnahmen zur sicheren Beseitigung der Ursachen und des entstandenen Schadens. Durch die definierten Festpreise für die einzelnen Dienstleistungen/Pakete wird die Analyse und Beratung von Beginn an fest kalkuliert und angeboten.
Die einzelnen standardisierten Dienstleistungen sind nachfolgend beschrieben. Details zur Preisgestaltung entnehmen Sie bitte aus der Preisliste, die wir Ihnen auf Anforderung gern zur Verfügung stellen.
Zur Untersuchung der Ursache für die Schimmelbildung in Wohngebäuden gibt es verschiedene Vorgehensweisen, die wir zu sinnvollen Dienstleistungspaketen zusammengefasst haben. Das gleiche gilt auch für die unterschiedlichen Methoden zur Bestimmung der Keimbelastung im Material oder in der Luft. Vor der eigentlichen Schimmelanalyse erfolgt daher eine kurze Beratung über die sinnvollste Methode zur Erfassung des Problems und insbesondere zur Festlegung der Maßnahmen zur sicheren Beseitigung der Ursachen und des entstandenen Schadens. Durch die definierten Festpreise für die einzelnen Dienstleistungen/Pakete wird die Analyse und Beratung von Beginn an fest kalkuliert und angeboten.
Die einzelnen standardisierten Dienstleistungen sind nachfolgend beschrieben. Details zur Preisgestaltung entnehmen Sie bitte aus der Preisliste, die wir Ihnen auf Anforderung gern zur Verfügung stellen.
Schimmelberatung vor Ort, ohne schriftlichen Bericht
 Klärung der Ursachen für die Schimmelpilzbildung inkl. Messungen des Raumklimas, der Oberflächentemperaturen und Materialfeuchten. Die Ursachen und die möglichen Lösungen zur Schimmelpilzbeseitigung werden mündlich mit den betroffenen Bewohnern besprochen. Es wird kein schriftlicher Bericht erstellt. Bei Feuchtigkeitsschäden, die sich nicht eindeutig erklären lassen, können nach Vereinbarung weitere Untersuchungen erforderlich sein.
Klärung der Ursachen für die Schimmelpilzbildung inkl. Messungen des Raumklimas, der Oberflächentemperaturen und Materialfeuchten. Die Ursachen und die möglichen Lösungen zur Schimmelpilzbeseitigung werden mündlich mit den betroffenen Bewohnern besprochen. Es wird kein schriftlicher Bericht erstellt. Bei Feuchtigkeitsschäden, die sich nicht eindeutig erklären lassen, können nach Vereinbarung weitere Untersuchungen erforderlich sein.
Basis- Schimmelanalyse
 Klärung der Ursachen für die Schimmelpilzbildung inkl. Messungen des Raumklimas, der Oberflächentemperaturen und Materialfeuchten. Die Ursachen werden in einem Bericht erklärt und durch Berechnungen belegt. Im Bericht werden mehrere Vorschläge zur Sanierung des Schadenfalls gegeben. Um Wasserschäden durch Leckagen zu ermitteln, werden in Abstimmung mit dem Auftraggeber Fachfirmen zur Leckageortung hinzugezogen.
Klärung der Ursachen für die Schimmelpilzbildung inkl. Messungen des Raumklimas, der Oberflächentemperaturen und Materialfeuchten. Die Ursachen werden in einem Bericht erklärt und durch Berechnungen belegt. Im Bericht werden mehrere Vorschläge zur Sanierung des Schadenfalls gegeben. Um Wasserschäden durch Leckagen zu ermitteln, werden in Abstimmung mit dem Auftraggeber Fachfirmen zur Leckageortung hinzugezogen.
Langzeitmessung
 Bei der Langzeitmessung wird über einen Zeitraum von 1-2 Wochen ein Datenlogger aufgestellt, der die Lufttemperatur, Luftfeuchtigkeit und ggf. die Oberflächentemperatur in kurzen Abständen von 1-2 Minuten über den Zeitraum von 1-2 Wochen aufnimmt. Mit dieser Methode ergeben sich Rückschlüsse auf das Nutzerverhalten oder sporadisch auftretende Ereignisse.
Bei der Langzeitmessung wird über einen Zeitraum von 1-2 Wochen ein Datenlogger aufgestellt, der die Lufttemperatur, Luftfeuchtigkeit und ggf. die Oberflächentemperatur in kurzen Abständen von 1-2 Minuten über den Zeitraum von 1-2 Wochen aufnimmt. Mit dieser Methode ergeben sich Rückschlüsse auf das Nutzerverhalten oder sporadisch auftretende Ereignisse.
Berechnung des MindestwÄrmeschutzes
 Bei der Berechnung des Mindestwärmeschutzes wird der Wandaufbau nach seinen U-Wert (Kennwert für die Dämmung) berechnet. Wenn der Mindestwärmeschutz nicht gegeben ist, kann es zu Schimmelschäden durch Kondensation der Luftfeuchtigkeit an den Bauteiloberflächen kommen. Ein Mindestwärmeschutz muss in Wohngebäuden eingehalten werden, die nicht zur Eigennutzung dienen,. Das bedeutet dass die Außenwände, Fenster, Dach und Kellerdecke energetisch saniert werden müssen, wenn der Mindestwärmeschutz nicht eingehalten wird.
Bei der Berechnung des Mindestwärmeschutzes wird der Wandaufbau nach seinen U-Wert (Kennwert für die Dämmung) berechnet. Wenn der Mindestwärmeschutz nicht gegeben ist, kann es zu Schimmelschäden durch Kondensation der Luftfeuchtigkeit an den Bauteiloberflächen kommen. Ein Mindestwärmeschutz muss in Wohngebäuden eingehalten werden, die nicht zur Eigennutzung dienen,. Das bedeutet dass die Außenwände, Fenster, Dach und Kellerdecke energetisch saniert werden müssen, wenn der Mindestwärmeschutz nicht eingehalten wird.
Luftkeimsammlung
 Die Luftkeimsammlung wird eingesetzt, wenn ein versteckter Schimmel-schaden vermutet wird oder als Überprüfung der Wirksamkeit einer abgeschlossenen Schimmelpilzsanierung. Bei der Luftkeimsammlung werden Luftsporen nach einem standardisierten Verfahren gesammelt und kultiviert. Die Luftsporen werden dabei direkt auf zwei unterschiedlichen Nährböden aufgetragen. Um die Belastung in Innenräumen zu bestimmen, werden auch Proben der Außenluft genommen, denn in der Luft befinden sich immer Schimmelsporen und nur der Vergleich der beiden Proben kann auf einen versteckten Schimmelbefall hindeuten.
Die Luftkeimsammlung wird eingesetzt, wenn ein versteckter Schimmel-schaden vermutet wird oder als Überprüfung der Wirksamkeit einer abgeschlossenen Schimmelpilzsanierung. Bei der Luftkeimsammlung werden Luftsporen nach einem standardisierten Verfahren gesammelt und kultiviert. Die Luftsporen werden dabei direkt auf zwei unterschiedlichen Nährböden aufgetragen. Um die Belastung in Innenräumen zu bestimmen, werden auch Proben der Außenluft genommen, denn in der Luft befinden sich immer Schimmelsporen und nur der Vergleich der beiden Proben kann auf einen versteckten Schimmelbefall hindeuten.
Nach Abschluss von Sanierungsarbeiten wird die Luftkeimsammlung angewendet, um die korrekte Sanierung zu bestätigen.
Klebeproben
 Bei den Klebeproben werden Schimmelpilzprobenmit einer durchsichtigen und klebenden Kunststofffolie aufgenommen. Die Kunststofffolien werden hierzu auf die betroffenen Flächen geklebt und fest angedrückt. Dabei bleiben auf der Klebefläche Sporen, Bakterien, Milben, Salzkristalle usw. kleben. Die Kunststofffolie wird dann auf einem Objektträger geklebt und anschließend im Labor mit einem Mikroskop untersucht. In der Regel sind dabei nur Pilzgattungen erfassbar, da charakteristische Strukturen auf natürlichen Substraten fehlen.
Bei den Klebeproben werden Schimmelpilzprobenmit einer durchsichtigen und klebenden Kunststofffolie aufgenommen. Die Kunststofffolien werden hierzu auf die betroffenen Flächen geklebt und fest angedrückt. Dabei bleiben auf der Klebefläche Sporen, Bakterien, Milben, Salzkristalle usw. kleben. Die Kunststofffolie wird dann auf einem Objektträger geklebt und anschließend im Labor mit einem Mikroskop untersucht. In der Regel sind dabei nur Pilzgattungen erfassbar, da charakteristische Strukturen auf natürlichen Substraten fehlen.
Diese Methode eignet sich auch für die Staubprobe, wobei diese Methode nicht sehr genau ist, da sich im Staub über längere Zeiten Sporen ansammeln können.
Klebefilmpräparate können im Labor relativ schnell analysiert werden, da sie nicht auf Nährböden angezüchtet werden.
OberflÄchentest / Abklatschproben
Die Abklatschproben sind einfach zu entnehmen und sind preiswert bei der Untersuchung im Labor. Der Nachteil ist dabei, dass die Proben 7-14 Tage im Labor angezüchtet werden müssen und somit keine schnelle Aussage zum Schimmelbefall abgegeben werden kann. Die Differenzierung nach Schimmelarten ist dabei zum Teil möglich. Die Proben werden wie bei der Klebeprobe direkt an Schadstelle aufgenommen. Dabei werden 2 unterschiedliche Nährböden direkt auf die Schadstelle gedrückt, danach luftdicht verpackt und im Labor weiter behandelt und untersucht.
Die Abklatschproben sind einfach zu entnehmen und sind preiswert bei der Untersuchung im Labor. Der Nachteil ist dabei, dass die Proben 7-14 Tage im Labor angezüchtet werden müssen und somit keine schnelle Aussage zum Schimmelbefall abgegeben werden kann. Die Differenzierung nach Schimmelarten ist dabei zum Teil möglich. Die Proben werden wie bei der Klebeprobe direkt an Schadstelle aufgenommen. Dabei werden 2 unterschiedliche Nährböden direkt auf die Schadstelle gedrückt, danach luftdicht verpackt und im Labor weiter behandelt und untersucht.
Materialproben
 Definierte Probenmengen werden entnommen und auf ein oder mehrere Nährböden gebracht. Evtl. Ist es erforderlich, auch Verdünnungsreihen anzulegen. Der Untersuchungsaufwand ist sehr hoch und daher verhältnismäßig teuer. Materialproben müssen dann genommen werden, wenn man vom Schaden keine Oberflächenproben entnehmen kann (z.B. bei der Trittschalldämmung, Innendämmung, Estrich, Gipskartonplatten usw.). Dies trifft auch zu, wenn vermutet wird, dass sich der Schimmelpilzschaden nicht nur auf der Oberfläche des Bauteils befindet, sondern auch weit ins Bauteilinnere reicht, z.B. zur Entscheidungsfindung, in welchem Umfang Sanierungsmaßnahmen erforderlich sind.
Definierte Probenmengen werden entnommen und auf ein oder mehrere Nährböden gebracht. Evtl. Ist es erforderlich, auch Verdünnungsreihen anzulegen. Der Untersuchungsaufwand ist sehr hoch und daher verhältnismäßig teuer. Materialproben müssen dann genommen werden, wenn man vom Schaden keine Oberflächenproben entnehmen kann (z.B. bei der Trittschalldämmung, Innendämmung, Estrich, Gipskartonplatten usw.). Dies trifft auch zu, wenn vermutet wird, dass sich der Schimmelpilzschaden nicht nur auf der Oberfläche des Bauteils befindet, sondern auch weit ins Bauteilinnere reicht, z.B. zur Entscheidungsfindung, in welchem Umfang Sanierungsmaßnahmen erforderlich sind.
